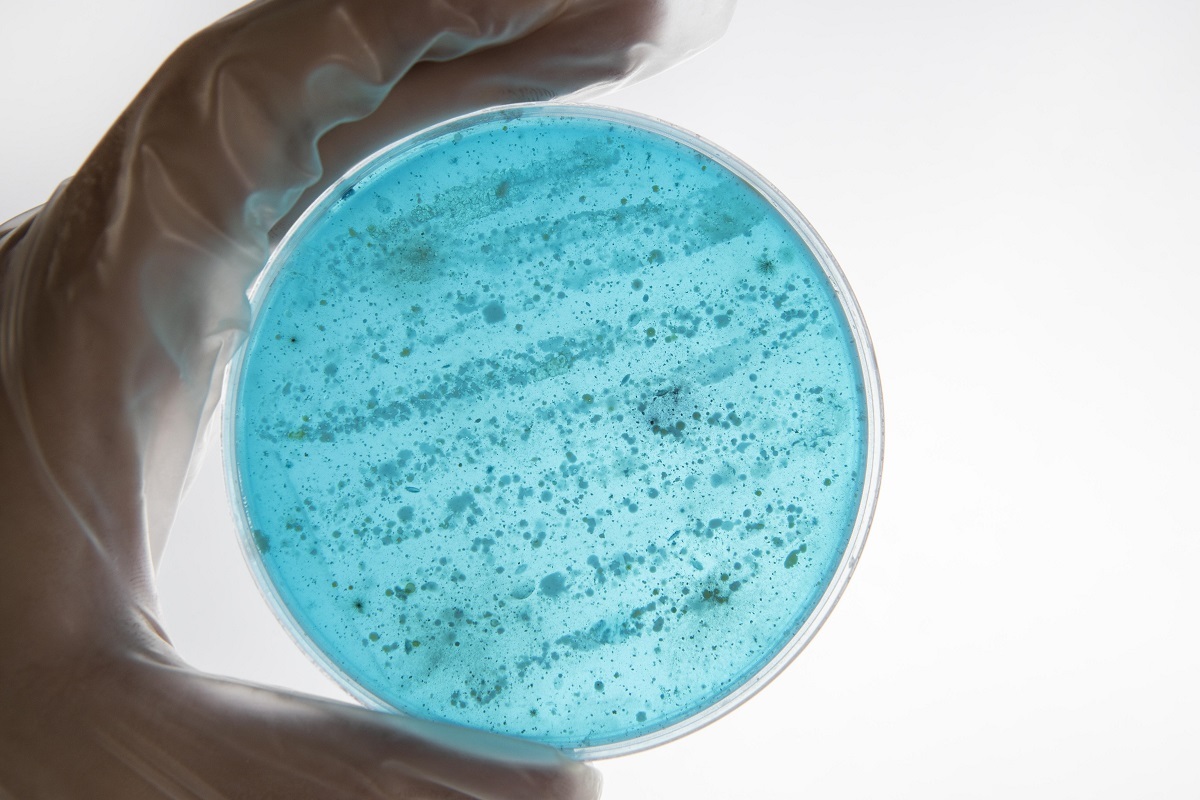

-
Нейробиологи СПбГУ выяснили, как мозг компенсирует нехватку дофамина при тяжелых нейродегенеративных заболеваниях
Ученые Санкт-Петербургского государственного университета исследовали функциональные связи дофаминового транспортера с другими генами черного вещества в мозге и выявили ранее неизвестные компенсаторные...

-
Волгоградские фармакологи испытали перспективный препарат против шизофрении
Учёные Волгоградского государственного медицинского университета доказали высокую эффективность нового антипсихотического вещества. В отличие от клозапина, одного из самых сильных, но токсичных антипсихотиков...

-
Географ ПсковГУ объяснила, зачем современному человеку думать континентами
Кандидат географических наук, доцент кафедры географии ПсковГУ Наталья Теренина в рамках Всероссийского фестиваля «#Вместе с российской наукой» рассказала о том, как география превратилась из романтической...

-
Курильское озеро стало эволюционной лабораторией: одна рыба, три судьбы
Российские ученые обнаружили на Курилах уникальный природный эксперимент. В озере Глухое на острове Парамушир одна рыба — южная мальма — эволюционировала в три совершенно разные формы. Каждая выбрала свою...

-
Специалисты СПбГУ разработали отечественный инструмент для быстрой диагностики инфекций
Ученые СПбГУ создали программу Antimicro для обработки результатов анализа геномов микроорганизмов в биологических материалах. Разработка исследователей уникальна: она единственная в мире учитывает особенности...
-
Спутники фиксируют, как меняются мерзлотные ландшафты Севера Сибири
Красноярские ученые впервые подробно классифицировали ландшафты зоны вечной мерзлоты и зафиксировали масштабные изменения, вызванные изменением климата и промышленной нагрузкой в районе Норильска. Спутниковые...

-
Химики СПбГУ создали полимер для эффективной доставки генетических лекарств
Ученые из Санкт-Петербургского государственного университета и филиала НИЦ «Курчатовский институт» — ПИЯФ — Института высокомолекулярных соединений разработали нетоксичный и доступный полимер на основе...

-
В Сеченовском Университете запустят опытное производство медизделий из полимеров
В научно-технологическом парке биомедицины заканчивают создание опытно-промышленной площадки Центра инжиниринговых разработок Сеченовского Университета, где запустят мелкосерийное производство образцов...

Фотография для шапки блога:Если нужно, измените границы. Выбранная область будет представлена в шапке вашей страницы.























